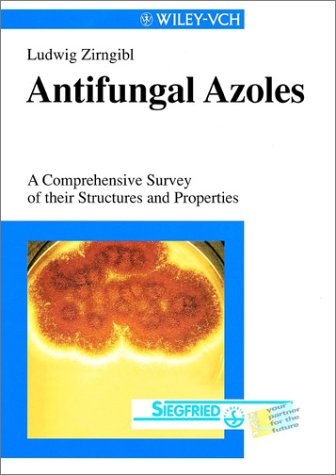

Azoles, Antifungal Active Substances: Syntheses and Uses
L. Zirngibl
L. Zirngibl
Publisher: Wiley-VCH Verlag GmbH
Number Of Pages: 300
Publication Date: 1998-05
Description: Number Of Pages: 300
Publication Date: 1998-05
Azoles are central ingredients in many drugs. They play an important role in the fight against skin deseases and the secondary symptoms of AIDS. They are also used in the protection of plants and in industry (leather, wool, fibers). The rapid development in this field affords a comprehensive handbook about their uses and applications.
The book covers the last 15 years of development of the title substances from a synthetic organic viewpoint based on over 2700 references (including 1350 patents) until October 1997. The author shows structure-activity relationships, activities and applications. The work will become an indispensable planning guide for researchers in the pharmaceutical industry and at universities.
http://mihd.net/spwvx7m/__7528b02__.html